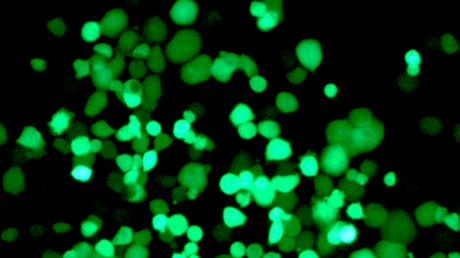
Crean un virus que ataca las células tumorales de forma selectiva

El tratamiento convencional del cáncer puede provocar efectos secundarios no deseados como consecuencia de su poca selectividad. Por ello, es importante que los nuevos tratamientos que se desarrollen sean capaces de eliminar de forma eficiente las células cancerígenas y preservar las células sanas.
En este sentido, las nuevas terapias en cáncer se basan en el desarrollo de virus modificados genéricamente para que solo puedan infectar a las células tumorales. El problema es que cuanto más potente es el virus, mayor es también la toxicidad asociada. Así, limitar este efecto sobre las células sanas es la clave para la aplicación de este tipo de terapias.
Ahora, científicos del Instituto de Investigaciones August Pi i Sunyer (IDIBAPS) y del Instituto de Investigación Biomética (IRB) de Barcelona han conseguido crear un virus que ataca de forma selectiva a las células tumorales sin que las sanas se vean afectadas. Los resultados se han comprobado en cultivos de laboratorio y con ratones, pero si se confirman en personas, el virus podría ser un tratamiento útil para cánceres que tienen un mal pronóstico.
Un virus que solo destruye las células cancerígenas
En esta investigación, cuyos resultados se han publicado en la revista 'Nature Communications', los investigadores han modificado el genoma de un adenovirus - un tipo de virus muy común - para que solo pueda multiplicarse en las células cancerígenas. De esta manera, cuando entra en una célula sana, no le provoca ningún daño. En cambio, cuando entra en una célula tumoral es capaz de producir una gran cantidad de nuevos virus que provocan la destrucción de la célula.
Esta acción selectiva se ha conseguido a través de una familia de cuatro proteínas llamadas CPEBs. En estudios anteriores, los investigadores ya habían demostrado que las células cancerígenas suelen tener niveles altos de la proteína CPEB4, mientras que la CPEB1 suele estar presente en células sanas.
"Hemos aprovechado este desbalanceo para hacer un virus que solo ataca a las células con niveles altos de CPEB4 y bajos de CPEB1, con lo que solo afecta a las células tumorales, ignorando las sanas", explica Raúl Méndez, investigador del IRB Barcelona.
Así, los científicos comprobaron la actividad del virus creado en modelos de in-vitro de cáncer de páncreas y se observó un control del crecimiento del tumor en modelos de ratón. "Cuando los virus modificados entraban en las células tumorales, replicaban su genoma y, al salir, destruían la célula liberando más partículas del virus, capaces de infectar, a su vez, a más células cancerígenas", explica Cristina Fillat, jefa del grupo terapia Génica y Cáncer del IDIBAPS.
Según los investigadores, esta estrategia oncoselectiva podría ser válida para otros tumores sólidos y, además, combinada con otras terapias, podría ser muy eficaz en el control del tumor. Así, si estos resultados se confirman en un futuro en personas, el virus podría convertirse en un tratamiento útil para cánceres que hoy día tienen mal pronóstico.